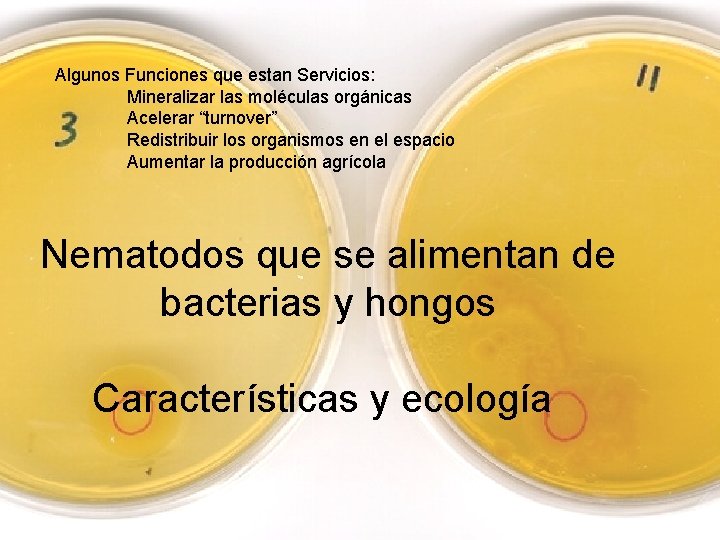
Algunos Funciones que estan Servicios: Mineralizar las moléculas orgánicas Acelerar “turnover” Redistribuir los organismos

Ecologa de Nematodos y Salud de Suelo Clase

- Slides: 24
Ecología de Nematodos y Salud de Suelo Clase 5 Nematodos que se alimentan de bacterias y hongos Howard Ferris Ignacio Cid del Prado Alejandro Esquivel Walter Peraza Gabriela Soto
Dia 3: Jueves 16 de julio Hora Tema 8 a 9 Recapitulación del día anterior 9 a 10. 30 • 10. 30 a 12 Laboratorio: • Muestreo de nematodos de diferentes ecosistemas • Extracción e identificación a nivel de familia o genero Bacteriovoros y micofagos 12 a 1 Almuerzo* 1 a 2. 30 Depredadores Responsable Gabriela Soto Ignacio Cid del Prado Howard Ferris Ignacio Cid del Prado Alejandro Esquivel Howard Ferris 2. 30 a 5 Laboratorio: • Muestreo de nematodos de diferentes ecosistemas • Extracción y identificación a nivel de familia Ignacio Cid del Prado Alejandro Esquivel Howard Ferris 6: 30 a 8 Seminario y Discussion: Biología, Ecología y Gestión Sustentable de los Nematodos de Tomate y Legumbres Ignacio Cid del Prado
Los Nematodos de vida libre parásitos de animales parásitos de plantas marinos
Diversidad Funcional de los Nematodos
Algunos Funciones que estan Servicios: Mineralizar las moléculas orgánicas Acelerar “turnover” Redistribuir los organismos en el espacio Aumentar la producción agrícola Nematodos que se alimentan de bacterias y hongos Características y ecología
Distribución de los organismos a nuevos recursos ecología del comportamiento bacteria y nematodos bacteriovoros 5 nematodos Células Bacterianas 0 nematodos Abundancia de Nematodos Fu et al. 2005 20 nematodos
Distribución de los organismos a nuevos recursos y la regulación biológica Los hongos capturan nematodos a través de: 1. trampas, redes y hifas adhesivas 2. esporas que se desprenden de las hifas
La explotación de servicios de los ecosistemas: El servicio N-mineralización de los nematodos bacteriófagos Mineralization Nitrogéno
C C: N = 4: 1 N C: N = 6: 1 bacteria nematodo bacteriovoro
Teniendo al campo……. . . Manejo de la Cadena Alimenticia – un experimento Cultivo de cobertura Irrigación temperatura humedad T 0 actividad M 0 Ferris et al. , 2004
complementariedad Un Gremio Funcional diversa de bacterió apoya…. continuidad Ferris et al. , 2004
Clasificación Actual de los Nematodos (basados en la ssu r. DNA) Nematoda Enoplea Chromadorea Enoplida Enoplia Dorylaimida Dorylaimia Marine / freshwater environments, Freshwater or and terrestrial habitats, moist terrestrial habitats. some marine. Dorylaimida Feed as. Enoplida predators or on bacteria, Feed as predators or on fungi, algae diatoms and algae. and higher plants. Triplonchida Mononchida Triplonchida Mermithida Freshwater and terrestrial habitats, Terrestrial habitats and some marine. freshwater sediments. Feed as predators or on bacteria, Predators of. Mononchida other nematodes. fungi, algae and higher plants. Dioctophymatida clase (ea) subclase (ia) orden (ida) suborden (ina) superfamilia (oidea) familia (idae) subfamilia (inae) per De Ley & Blaxter, 2002 Trichinellida Isolaimida Terrestrial habitats. Isolaimida Bacterial feeders. Muspiceida Marimerthida Chromadoria Rhabditida Parasites of plants and animals and bacterial- and. Rhabditida fungal-feeders. Plectida Soil and freshwater nematodes. Soil, marine and freshwater nematodes. Araeolaimida Plectida Bacterial unicellular feeders. Marine orand inhabit brackish water Monhysterida inhabitants. Marine, brackish, freshwater, some Araeolaimida Many are bacterivores and some may soil forms. Desmodorida feed on algae. Feed bacteria, algae and otherand Mainlyonmarine, some in brackish Monhysterida organisms. freshwater. feeding probably bacteria, diatoms and Desmoscolecida unicellular. Desmodorida eucaryotes Typically marine, some freshwater and. soil forms Feeding. Desmoscolecida probably bacteria, diatoms Chromadorida and unicellular eucaryotes Mainly marine and freshwater, some Chromadorida soil forms. Feed on bacteria, and probably on diatoms and unicellular eucaryotes. .
Clasificación por Gremios Estructurales Serie de colonizadores y persistentes (cp) oportunismo estructura enriquecimiento 1 Bongers estabilidad 2 3 4 5 Bongers, 1990
Clasificación por Gremios Funcionales Bongers cp 1 2 3 4 5 Trophic Role Ba 1 Ba 2 Ba 3 Ba 4 Ba 5 Bacteriovoros Fu 1 Fu 2 Fu 3 Fu 4 Fu 5 Micofagos Om 3 Om 4 Om 5 Omnivoros Pr 3 Pr 4 Pr 5 Pr 2 Depredadores Gremios Funcionales son la combinación de los hábitos de alimentación y las características de su ciclo de vida Los omnivoros son depredadores generalistas
Clasificación por Gremios Funcionales Indicadores de Enriquecimiento Indicadores de Estructura Rhabditidae Panagrolaimidae etc. Ciclo de vida corto Cuerpos peq. a medianos Fauna Basal Alta fecundidad Huevos pequeños Cephalobidae Dauer larva Aphelenchidae, etc. Amplia amplitud ecologico Oportunistas Condiciones perturbado Ciclo de vida corto Cuerpo mediano Tolerantes al estrés Adaptaciones por alimentación Presente en todos suelos Aporcelaimidae Nygolaimidae etc. Ciclo de vida largo Cuerpos grandes Baja fecundidad Huevos grandes El estrés intolerantes Estrecha amplitud Condiciones inalteradas
Aphelenchus cp 2 micofagos Acrobeles oportunistas generales bacteriovoros Tylencholaimellus cp 4 cp 3 cp 2 Acrobeloides Diphtherophora
Rhabditidae – bacteriófagos - cp 1 – enriquecimiento oportunista Rhabditida Rhabditiidae
Panagrolaimus – bacteriófago cp 1 – enriquecimiento oportunista Rhabditida Panagrolaimidae Rhabditida Cephalobidae Acrobeloides – bacteriófago cp 2 – oportunista general
Metateratocephalus crassidens Photo: Hanny van Megen Monhystera sp. Photo: Hanny van Megen Monhysteridae Plectida Teratocephalidae Acrobeles sp. Rhabditida Cephalobidae
Bacteriófagos: ejemplos de los estomas e ornamentación de la cabeza Cephalobidae Rhabditidae
ejemplos de los esófagos bacteriófago
Fungivoros: ejemplos de los estiletes y esófagos Aphelenchoides Tylencholaimellus Aphelenchus Diphtherophora
Anomyctus Photo: Hanny van Megen
la transformación de los recursos y la sucesión de nematodos Suplemento de C Transformación del recurso Estructura de comunidad cambia Ferris and Matute (2003)